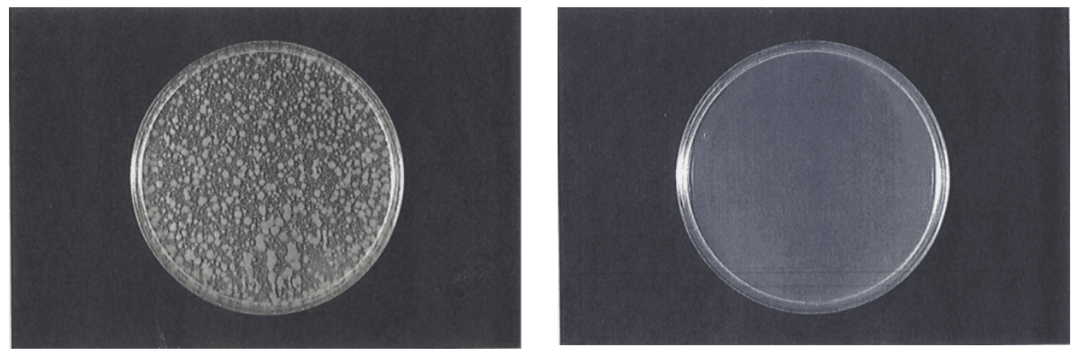
神奇的強堿性電解水……(圖10)

通常情況下電解水的類型是依據(jù)pH值進行劃分的,我們按照pH值的不同,可以將電解水分為強酸性電解水(也稱酸性氧化電位水)、弱酸性電解水、微酸性電解水、中性電解水、弱堿性電解水和強堿性電解水,如下圖:

Fig1 電解水的分類
采用隔膜法電解產(chǎn)生酸性電解水的同時,陰極側(cè)會產(chǎn)生強堿性電解水。強堿性電解水又稱強堿性電解離子水,是指pH值高于11.0的電解水(用于工業(yè)清洗時,其pH值可以達到13.0左右),其有效成分為NaOH/KOH,含有活性氫,可有效去除脂質(zhì)和蛋白質(zhì)等污垢。
強堿性電解水設備采用隔膜式電解槽,電解質(zhì)一般為K2CO3,其電解質(zhì)也可采用NaCl或KCl,與強酸性電解水一起產(chǎn)生。
不同于其他由苛性鈉而形成的堿性水,強堿性電解水不會導致皮膚的刺激性或化學性灼傷。除了其殺菌效果,超級堿性電離水對分解油非常有效,因此廣泛地使用在清洗制造產(chǎn)品及工業(yè)機械和零件,以及CIP清洗。
強堿性電解水的生成主要有兩種方式,一種是隔膜式電解槽電解氯化鈉溶液時所產(chǎn)生的陰極液(陽極液主要成分為次氯酸),另一種是隔膜式電解槽循環(huán)電解碳酸鈉或碳酸鉀溶液。

Fig2 強堿性電解水的生成方式(一)

Fig3 強堿性電解水的生成方式(二)
皂化作用:油或其他脂肪遇上強堿電解水,便會被分解,通過皂化作用,使油脂類污染物成為更容易脫離的狀態(tài)。

乳化分散作用:堿性電解水通過乳化作用將油脂類污染物切割分散,使其更容易剝落。

污染物脫離作用:在堿性電解水的作用下,多數(shù)污染物離子具有很強的負電位,同時許多待清洗物體表面也帶有負電荷,兩者之間產(chǎn)生排斥力,具有較強的去污作用。另外,這種排斥力也可以防止待清洗物體表面再次受到污染。

溶解氫作用:在堿性電解水中含有豐富的溶解氫,其對污染物去除也具有一定作用。

小分子團特性:水分子是一種高極性分子,由于氫鍵的作用,使水以水分子團的形式呈液態(tài)存在,并且這種水分子團會不斷地聚散離合(如下圖所示),在局域離子形成的電場力作用下,極性水分子會圍繞著某個離子形成分子群團化,當電場達到一定的強度,且有一定濃度的離子做支架時,就會將大分子團的水變成小分子團的水,因此具有更好的滲透性。

Fig4 強堿性電解水小分子特性
強堿性電解水因其較高的pH值,能夠水解病原菌的蛋白質(zhì)和核酸,破壞細菌的正常代謝機能,使細菌死亡,其殺菌作用強大,并能殺滅病毒。
Fig5 強堿性電解水(pH12.5)作用30s殺菌效果
強堿性電解水中氫氣分子過飽和溶解,氧化還原電位很低,溶解氧也非常少,所以可以防止液體中金屬生銹形成氫氧化鐵膜。

※注意:不能用于對堿有反應的金屬(鋁、黃銅、銅等)。
堿性電解水濕巾:堿性電解水清潔濕巾在日本早有應用,主要用作表面清潔,可去除多種有機污染物和油污,同時不會有任何殘留,用后無需二次清潔。

多功能清潔液:強堿性電解水作為多功能清潔液在日本和國內(nèi)多有應用,主要用作廚房油污去除、果蔬農(nóng)殘去除等。

眼鏡清潔護理液:以強堿性電解水為清潔護理液可以用作眼鏡,手機、電腦等電子設備屏幕的清潔和殺菌。

寵物用清潔護理液:堿性電解水作為寵物清洗護理液,主要用于寵物毛發(fā)清潔、體表殺菌、除臭等。

雖然強堿性電解水可以作為主要成分制成以上產(chǎn)品,但是要注意根據(jù)不同用途,需用選擇不同pH值,同時在某些特殊用途時,需添加其他復合成分。
另外,強堿性電解水在工業(yè)玻璃清洗、金屬零部件清洗、PCB板清洗、織物清洗、醫(yī)療器械清洗、蛋白質(zhì)提取、農(nóng)藥殘留去除等方面都有應用,接下來的文章我們會為大家詳細介紹,敬請期待……
銷售服務熱線:400-029-2090
公司總臺電話:400-029-2090轉(zhuǎn)4
售后服務專線:400-029-2090轉(zhuǎn)3 17316607625(微信同號)
官方郵箱地址:xd@xindianmedical.com
官方微信公眾號:XD83336449(或公眾號搜索“信點醫(yī)療”)
公司營銷中心地址:中國?西安高新區(qū)高新一路25號創(chuàng)新大廈N701-703室